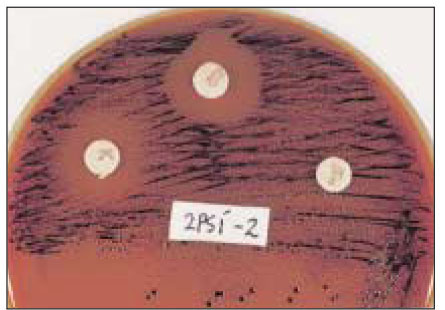
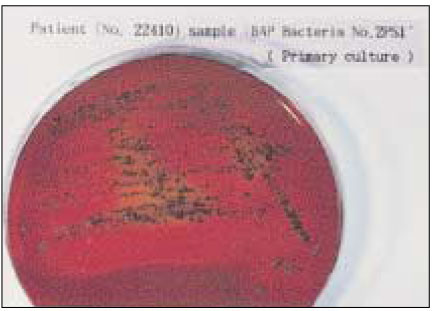
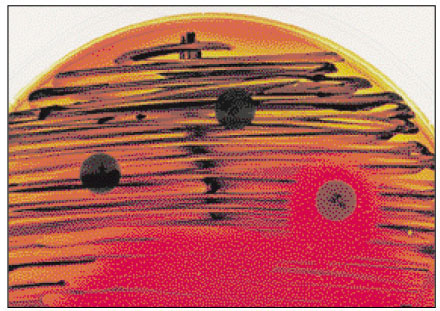
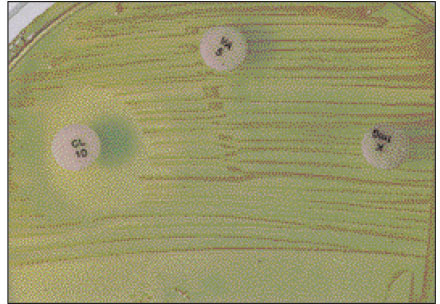

Articles
- Page Path
- HOME > Restor Dent Endod > Volume 27(1); 2002 > Article
- Original Article Detection of black-pigmented bacteria in infected root canals
- Eun-Kyoung Kwon, Eun-Sook Kim, Ju-Seog Kwak, Hwang Lee, Su-Jong Lee, Mi-Kyung Im
-
2002;27(1):-65.
DOI: https://doi.org/10.5395/JKACD.2002.27.1.054
Published online: January 31, 2002
Department of Conservative Dentistry, College of Dentistry, Wonkwang University, Korea.
Copyright © 2002 Korean Academy of Conservative Dentistry
- 1,624 Views
- 4 Download
Abstract
-
Black-pigmented bacteria have been implicated in the endodontic infections. This group of microorganisms includes Porphyromonas endodontalis, Porphyromonas gingivalis, Prevotella intermedia, and Prevotella nigrescens. The organisms display a wide variety of virulence factors that may be pertinent to acute endodontic infections.The aim of this study was to identify P. endodontalis, P. gingivalis, P. intermedia, and P. nigrescens by using special potency disk test, filter paper spot test, 16S rRNA gene-directed PCR, and API 32A.Microbial samples were collected from root canals of 33 intact teeth with necrotic pulp and/or apical periodontitis. Conventional laboratory methods were used for identification of the strains of black pigmented bacteria. Eighteen of 33 samples were positive for the growth of black-pigmented bacrteria. Five colonies were cultured from each pure cultured colonies from Brucella agar plate. Seventy seven colonies were positive for the growth of black-pigmented bacteria.Thirty three of 77(42.6%) were identifed as P. nigrescens, 10 of 77(12.9%) were P. gingivalis, 6 of 77(7.8%) were P. endodontalis, 10 of 77(12.9%) were P. intermedia. On the contrary the reference strains of P. nigrescens, experimental strains of P. nigrescens was sensitive to kanamycin in special potency disk test.16S rRNA gene PCR and API test after rapid presumptative identification methods, such as special potency disk test and filter paper spot test, would be accurate detection methods for black-pigemented bacteria.
- 1. Kakehashi S, Stanley HR, Fitzgerald RJ. The effects of surgical exposures of dental pulps in germ-free and conventional laboratory rats. Oral Surg. 1965;20: 340-349.ArticlePubMed
- 2. Brook I, Frazier EH, Gher ME. Aerobic and anaerobic microbiology of periapical abscess. Oral Microbiol Immunol. 1991;6: 123-125.ArticlePubMed
- 3. Zavistoski J, Dzink J, Onderdonk A, Bartlett J. Quantitative bacteriology of endodontic infections. Oral Surg. 1980;49: 171-174.ArticlePubMed
- 4. Winkelhoff V, Steenbergen TJM, Graaff J. The role of black-pigmented Bacteroides in human oral infections. J Clin Periodontol. 1998;15: 145-155.Article
- 5. Winkelhoff AJ, Steenbergen TJM, Kippuw N, Graaff J. Further characterization of Bacteroides endodontalis, an asaccarolytic black-pigmented bacteroides species from the oral S Cavity. J Clin Microbiol. 1985;22: 75-79.ArticlePubMedPMCPDF
- 6. Oliveira JCM, Siqueira JF, Alves GB, Hirata R, Andrade AFB. Detection of Porphyromonas endodontalis in infected root canals by 16S rRNA gene-directed polymerase chain reaction. J Endod. 2000;26: 729-732.ArticlePubMed
- 7. Hofstad T. Pathogenicity of anaerobic gram-negative rods: possible mechanisms. Rev Infect Dis. 1984;6: 189-199.ArticlePubMed
- 8. Lamont RJ, Jenkinson HF. Life below the gum line: pathogenic mechanisms of Porphyromonas gingivalis. Microbiol Mol Biol Rev. 1998;62: 1244-1257.ArticlePubMedPMCPDF
- 9. Shah HN, Collis MD. Proposal for reclassification of Bacteroides asaccarolyticus, Bacteroides gingivalis, and Bacteroides endodontalis in a new genus, Porphyromonas. Int J Syst Bacteriol. 1988;38: 128-131.
- 10. Shah HN, Collins MD. Prevotella, a new genus to include Bacteroides melaninogenicus and related species formerly classified in the genus Bacteroides. Int J Syst Bacteriol. 1990;40: 205-208.PubMed
- 11. Winkelhoff AJ, Steenbergen TJM, Graaff J. Porphyromonas (Bacteroides) endodontalis:Its role in endodotal infections. J Endod. 1992;18: 431-433.PubMed
- 12. Steenbergen TJM, Winkelhoff AJ, Grenier D, Graff J. Bacteroides endodontalis sp. nov., an Asaccharolytic black-pigemented bacteroides species from infected dental root canals. Int J Syst Bacteriol. 1984;2: 118-120.
- 13. Slots J, Genco RJ. Direct hemagglutination technique for differentiating Bacteroides asaccarolyticus oral strains from nonoral strains. J Clin Microbiol. 1979;10: 371-374.ArticlePubMedPMCPDF
- 14. Herweijer JA, Loos BG, Neiders ME. Characterization of total membrane proteins of Porphyromonas endodontalis. J Endod. 1992;18: 620-624.ArticlePubMed
- 15. Stubbs S, Park SF, Bishop PA, Lewis MAO. Direct detection of Prevotella intermedia and P. nigrescens in suppurative oral infection by amplication of 16S rRNA gene. J Med Microbiol. 1999;18: 1017-1022.
- 16. Gharbia SE, Haapasalo M, Shah HN, Kotiranta A, Lounatmaa K, Pearce MA, Devine DA. Characterization of Prevotella intermedia and Prevotella nigrescens isolates from periodontic and endodontic infections. J periodontol. 1994;65: 56-61.ArticlePubMed
- 17. Shah HN, Gharbia SE. Biochemical and chemical studies on strains designated Prevotella intermedia and proposal of a new pigmented species, Prevotella nigrescens sp. nov. Int J Syst Bacteriol. 1992;42: 542-546.ArticlePubMed
- 18. Nisengard R, Newman MG. Oral microbiology and immunology. 1991;second edition. 213-216.
- 19. Baumgartner JC, Watkins BJ, Bae KS, Xia T. Association of black-pigmented bacteria with endodontic infections. J Endod. 1999;25: 413-417.ArticlePubMed
- 20. Bae KS, Baumgartner JC, Shearer TR, David LL. Occurence of Prevotella nigrescens and Prevotealls intermedia in infections of Endodontic Origin. J Endod. 1997;23: 620-623.PubMed
- 21. Sundqvist G, Johnasson E, Sjogren U. Prevalence of black-pigmented bacteroides species in root canal infections. J Endod. 1989;15: 13-19.ArticlePubMed
- 22. Siqueira JF, Rocas IN, Oliveira JCM, Santos KRN. Detection of putative oral pathogens in acute periradicular abscesses by 16S rDNA-directed polymerase chain reaction. J Endod. 2001;27: 164-167.ArticlePubMed
- 23. Siqueria JF, Rocas IN, Oliveira JCM, Santos KRN. Molecular detection of black-pigmented bacteria in infections of endodontic origin. J Endod. 2001;27: 563-566.ArticlePubMed
- 24. Kim YH, Kim SH. Diagnosis Clinical Microbiology. 2000;284-406.
- 25. Haapasalo M. Bacteroides spp. in dental root canal infections. Endod Dent Traumatol. 1989;5: 1-10.ArticlePubMed
- 26. Bogen G, Slots J. Black-pigmented anaerobic rods in closed periapical lesions. Int Endod J. 1999;32: 204-210.ArticlePubMedPDF
- 27. Slots J, Ashimoto A, Flynn MJ. Detection of putative periodontal pathogens in subgingival specimens by 16S ribosomal DNA amplication with the polymerase chain reaction. Clin Infect Dis. 1995;20: S304-S307.PubMed
- 28. Steenbergen TJM, Menard C, Tijhof CJ, Mouton C, Graaff J. Comparison of three molecular typing methods in studies of transmission of Porphyronas gingivalis. J Med Microbiol. 1993;14: 416-421.
- 29. Summanen P, Baron EJ, Citron DM, Strong CA, Wexler HM, Finegold SM. Wadsworth Anaerobic bacteriology Manual. 1993.
- 30. Moncla BJ, Braham P. Detection of sialidase (Neuraminidase) activity in actinomyces species by using 2'-(4-Methylumbelliferyl)α-D-N-Acetylneura-minic acid in a filter paper spot test. J Clin Microbiol. 1989;27: 182-184.ArticlePubMedPMCPDF
- 31. Moncla BJ, Braham P, Rabe LK, Hillier SL. Rapid presumptive identification of black-pigmented gram-negative anaerobic bacteria by using 4-methylumbelliferone derivatives. J Clin Microbiol. 1991;29: 1955-1958.ArticlePubMedPMCPDF
- 32. Slots J. Enzymatic characterization of some oral and nonoral gram-negative bacteria with the API ZYM system. J Clin Microbiol. 1981;14: 288-294.ArticlePubMedPMCPDF
- 33. Wayman BE, Murata SM, Almeida RJ, Fowler CB. A bacteriological and histological evaluation of 58 periapical lesions. J Endod. 1992;18: 152-155.ArticlePubMed
- 34. Matto J, Asikainen S, Vaisanen ML, Rautio M, Saarela M, Summanen P, Finegold S, Jousimies-Somer H. Role of Porphyromonas gingivalis,Prevotella intermedia, and Prevotella nigrescens in extraoral and some odontogenic infections. Clin Infect Dis. 1997;25: S194-S198.ArticlePubMed
REFERENCES

Tables & Figures
REFERENCES
Citations

Fig. 1
Fig. 2
Fig. 3
Fig. 4
Fig. 5
Fig. 6
Fig. 7
Fig. 8
Fig. 9
Special potency disk test on ATCC type strains
*R indicates resistant; S indicates sensitive
Special potency disk test on clinical isolates
*R indicates resistant; S indicates sensitive
Filter paper spot test on ATCC type strains
+, 90 to 100% of strains positive; -, 90 to 100% of strains negative
Filter paper spot test on clinical isolates
+, positive reaction observable after 15 min; -, No reaction detected after 15 min
Number of strains clinical isolates identified using PCR
*: total number of strains identified by PCR
Number of strains clinical isolates identified using RapidID 32A
*: total number of strains identified by PCR
*R indicates resistant; S indicates sensitive
*R indicates resistant; S indicates sensitive
+, 90 to 100% of strains positive; -, 90 to 100% of strains negative
+, positive reaction observable after 15 min; -, No reaction detected after 15 min
*: total number of strains identified by PCR
*: total number of strains identified by PCR

 KACD
KACD








 ePub Link
ePub Link Cite
Cite

